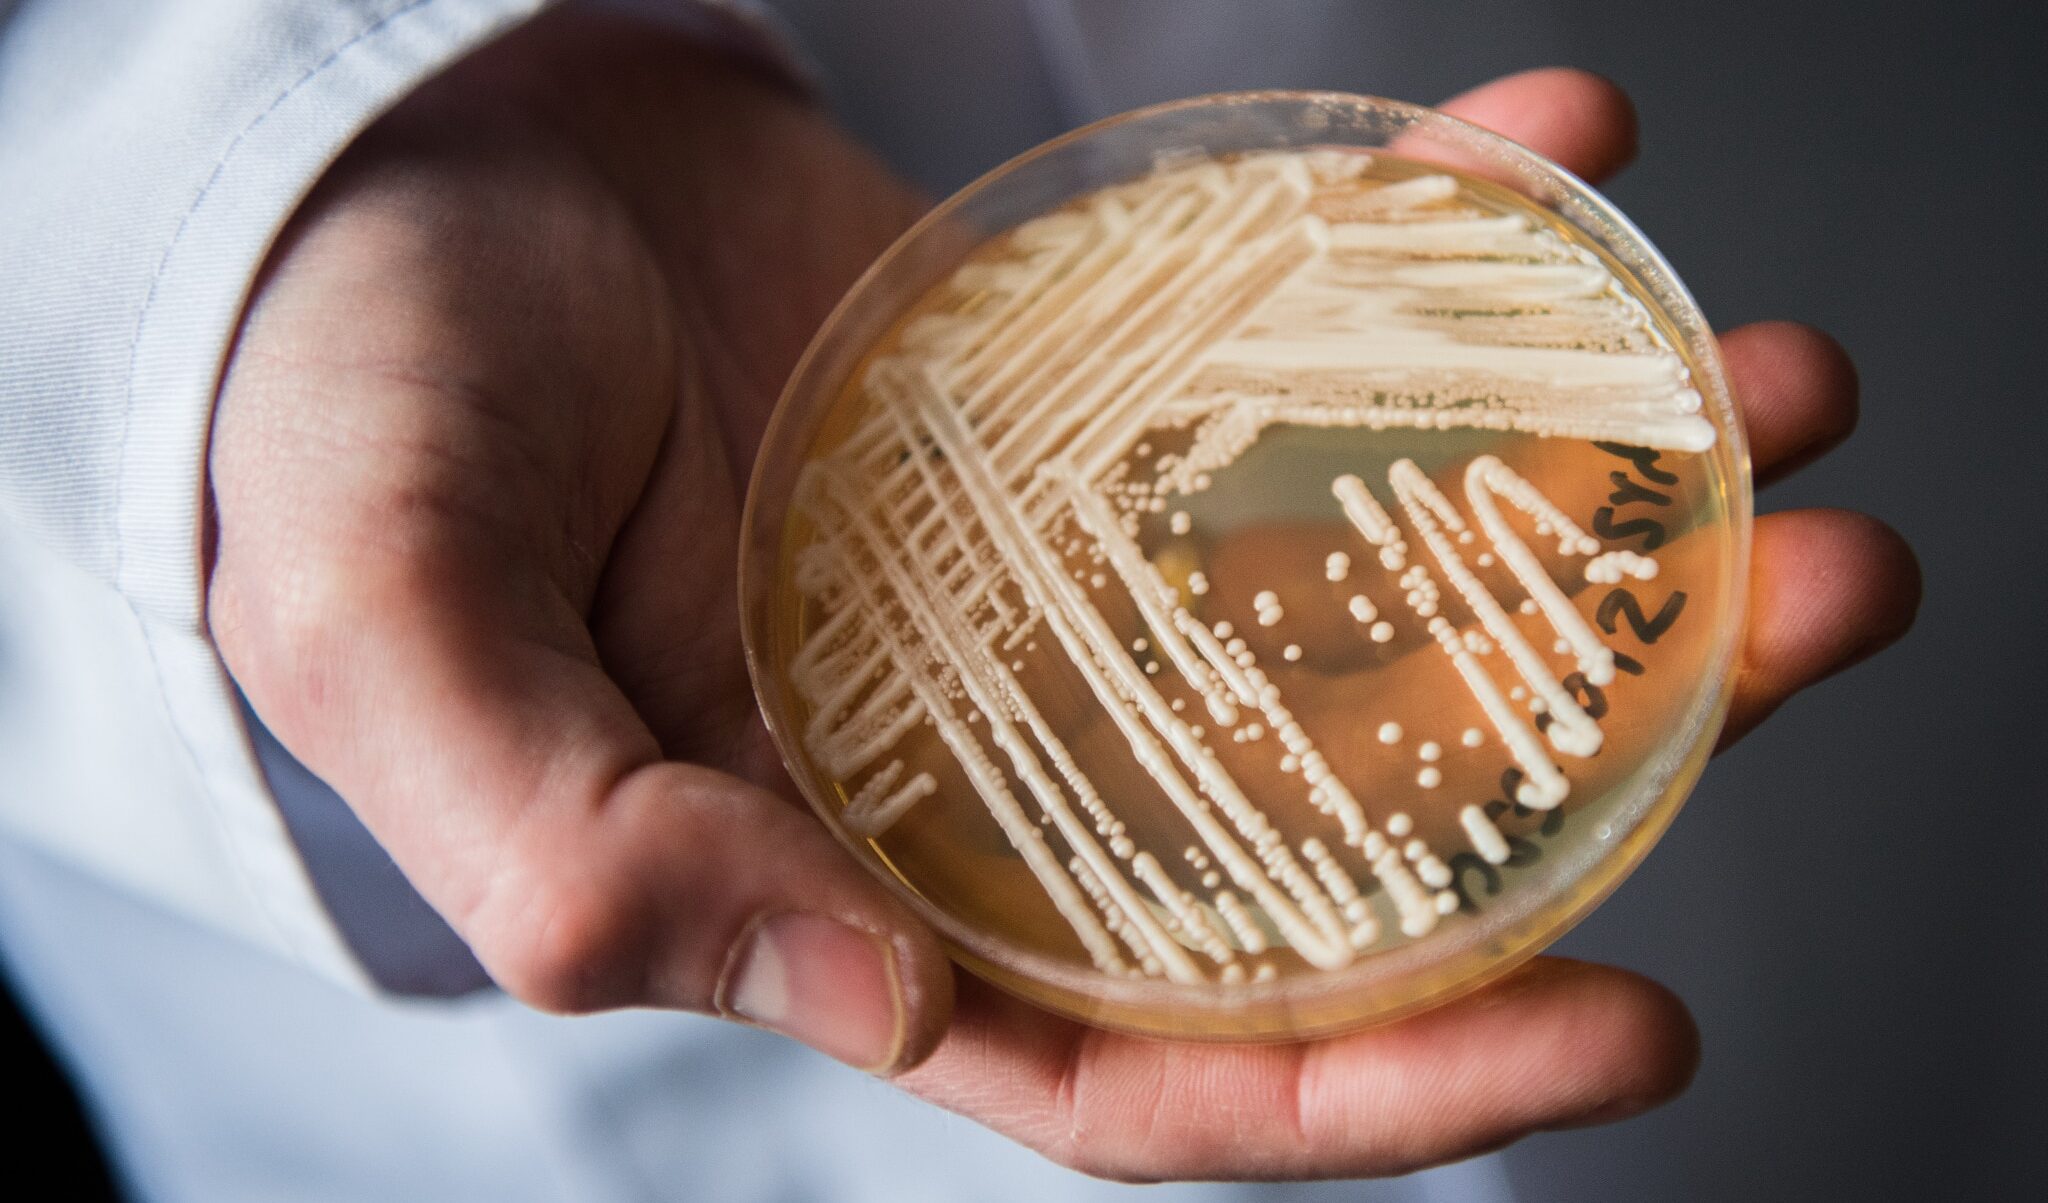

Tutto fortunatamente è andata per il verso giusto.
L’ex presidente americano Bill Clinton, ricoverato alcuni giorni fa in un ospedale californiano per un’infezione alle vie urinarie degenerata in setticemia, dovrebbe essere dimesso nelle prossime ore.
A farlo sapere è stato il portavoce Angel Urena, spiegando che le condizioni di Clinton stanno via via migliorando.
L’ex presidente era in California per una serie di eventi legati alla fondazione di famiglia.
Al momento del ricovero l’ex presidente, che ha 75 anni, è stato sistemato nel reparto di Terapia intensiva anche se, ha chiarito il portavoce, non è stato necessario prestargli cure intensive.
Da quando ha lasciato la Casa Bianca nel 2001, Clinton ha avuto diversi problemi di salute. Nel 2004 è stato sottoposto a un quadruplo bypass, nel 2005 è dovuto ricorrere alle cure mediche per via di un polmone parzialmente collassato, e nel 2010 gli sono stati impiantati un paio di stent in un’arteria coronaria.
A quel punto, l’ex presidente ha iniziato una dieta quasi totalmente vegana che, a suo dire, gli ha consentito di perdere peso e di migliorare le proprie condizioni di salute.